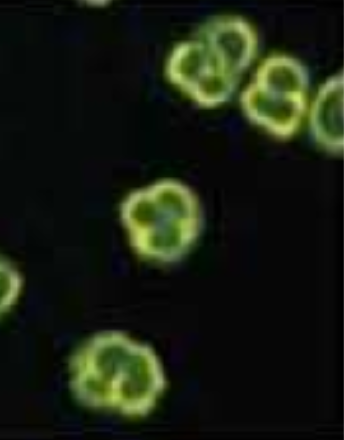

Loading
Archive
Recommended Articles
Overview of rheumatoid arthritis: Past lessons and future paths
Rheumatoid arthritis (RA) is a chronic autoimmune disorder that effects more than 1.3 million people in the United States. RA is an expensive disease that negatively impacts the patient’s quality of life. Inflammation of the synovial joints and destruction of articular cartilage and bones caused by RA can affect a patient’s ability to perform commonplace activities.
Using Self-Hypnosis to Improve Medical Compliance: The Role of Mind Body Modalities
Integrative medicine is the new kid on the block who is here to stay. Like the new kid at recess, integrative medicine has been met by some with open arms and eagerness for introductions by some, yet frank skepticism of differences by others.
Acute chikungunya fever followed by systemic lupus erythematosus
Chikungunya fever (CHIKF) is a viral disease caused by the chikungunya virus (CHIKV), a single-stranded positive-sense RNA virus in the Alphavirus genus of the Togaviridae family. Like many other arboviral diseases, it is transmitted by mosquito vectors, primarily Aedes aegypti and Aedes albopictus.
Rheumatoid arthritis – assessments and treatment recommendations
Rheumatoid arthritis (RA) is a chronic disease of yet unknown etiology causing joint tenderness, swelling, destruction and premature death. Extraarticular manifestations such as cervical spine involvement, bursitis, tendovaginitis, rheumatoid nodules, rheumatoid vasculitis, pulmonary fibrosis, and accelerated atherosclerosis - to name a few – may occur.
Psoriatic arthritis and cardiovascular disease
Psoriatic arthritis (PsA) is a chronic inflammatory skeletal and dermatological disease with heterogeneous clinical features and a strong relationship with spondyloarthritis group, sharing several genetic, clinical and radiographic characteristics and with a prevalence in the western country populations around 0.07-0.42.
Nutritional interventions and supplementation for rheumatoid arthritis patients: A systematic review for clinical application, Part 1: Dieting
Rheumatoid arthritis (RA) is a chronic, autoimmune disease that is associated with local and systemic inflammation, resulting in chronic pain and physical function limitations that may negatively impact quality of life (QOL). Despite advances in pharmacological therapies, currently available treatment options may be associated with adverse events and come at a high price tag.
Nutritional interventions and supplementation for rheumatoid arthritis patients: A systematic review for clinical application, Part 2: Supplementation
Rheumatoid arthritis (RA) is a chronic autoimmune disease that is associated with local and systemic inflammation, resulting in chronic pain and physical function limitations that may negatively impact quality of life (QOL). Despite advances in pharmacological therapies, currently available treatment options may be associated with adverse events and come at a high price tag.
Nutritional interventions and supplementation for rheumatoid arthritis patients: A systematic review for clinical application, part 3: Fruits and herbs
Rheumatoid arthritis (RA) is a chronic autoimmune disease that is associated with local and systemic inflammation, resulting in chronic pain and physical function limitations that may negatively impact quality of life (QOL). Despite advances in pharmacological therapies, currently available treatment options may be associated with adverse events and come at a high price tag.
Too early diagnosis of granulomatosis with polyangiitis (GPA) in the first month of initial presentation
Granulomatosis with Polyangiitis (GPA) is a systemic small sized vascular disease involving vasculitis, granuloma, and necrosis that most often targets the Ear, Nose and Throat (ENT) and/or Lungs and/or Kidneys, and it is classically associated with Anti-Neutrophil Cytoplasmic Antibody (ANCA) positivity.
Non-medical switching from originators to biosimilars in patients with rheumatic disease in routine clinical care: what is the best strategy?
Rheumatoid arthritis, ankylosing spondylitis and psoriatic arthritis are common rheumatic diseases leading to irreversible joint damage and increase in mortality. The introduction of highly effective biologic drugs has resulted in substantial benefit in the treatment of these diseases, but these therapies take a high toll on healthcare systems.
The effect of pharmacological treatment on rheumatoid arthritis related sarcopenia: A integrative review
Rheumatoid Arthritis (RA) is a systemic, chronic, inflammatory and erosive joint disease. Due the systemic effect mediated by increased serum pro-inflammatory cytokines, RA patients often present changes in body composition.
Chikungunya: an emerging rheumatological pandemic?
Chikungunya virus (CHIKV) has recently emerged alongside Ebolavirus, Zika virus, and SARS-CoV-2 as the causative pathogen for a global pandemic. CHIKV is a single-stranded RNA alphavirus that is transmitted by Aedes species mosquitos and has spread beyond its endemic regions in East Africa and South Asia through the Indian Ocean islands, into Southern Europe, and through the Caribbean and the wider Americas.
Therapy adherence in rheumatoid arthritis: A minireview
In the last decades there has been considerable progress in treatment, significantly improving quality of life, outcome and prognosis of rheumatoid arthritis (RA). Therapy adherence is a cornerstone of improved outcome. However, recent studies have shown that adherence may be low in a considerable percentage of patients.
Membrane complement regulatory protein CD59 in systemic lupus erythematosus and rheumatoid arthritis
Complement proteins constitute a proinflammatory system of the innate immunity which bridges with the adaptive immunity. It comprises of a group of serum zymogens, complement regulatory proteins (Cregs) and receptors.
Multicentric reticulohistiocytosis and its association with other autoimmune diseases: Review of cases from the point of view of rheumatologists
Multicentric reticulohistiocytosis (MRH) is a rare granulomatous disease manifesting by the subsequent appearance of erosive aggressive polyarthritis and typical skin papulonodular lesions. It can also affect internal organs such as the lungs, hearts in addition to rare cases of mesenteric lymphadenopathy and urogenital lesions.
Systemic sclerosis and challenges in COVID-19 pandemic
The Severe Acute Respiratory Syndrome Coronavirus 2 (SARS-CoV-2) led to a pandemic in the late 2019 and affected the worldwide population resulting in almost five million deaths and more than 200 million confirmed cases. Since the pandemic progressed, more studies shed light on the topic and researchers started speculating that comorbidities can increase the risk of adverse outcomes in COVID-19 disease.
Galantamine has a positive impact on joint collagen degradation process in collagen-induced arthritis
Galantamine is an alkaloid extracted from plant bulbs of some members of the Amaryllidaceae family and is a reversible competitive inhibitor of acetylcholinesterase. GAL affects the cholinergic anti-inflammatory pathway.
Dual targeting of plasma cells and B-cells to treat systemic lupus erythematosus
Autoimmune disorders, such as systemic lupus erythematosus, are associated with significant morbidity that is often ultimately refractory to current treatment modalities. To target the role of autoantibodies in disease pathogenesis, biologics have been designed for selective targeting of B-cells.
Sex differences in systemic lupus erythematosus: Epidemiology, clinical considerations, and disease pathogenesis
Systemic Lupus Erythematosus (SLE) is a chronic, multiorgan, systemic autoimmune disease that occurs more frequently in women than men and is typically diagnosed in women of reproductive age.
Prevalence and impact of obesity in patients with rheumatoid arthritis
Rheumatoid arthritis (RA) is chronic inflammatory arthritis characterized by the inflammation of multiple joints and significant joint destruction and disability. It is the most common form of inflammatory arthritis that affects synovial joints.